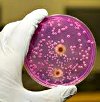

Говоря о молочнице, обычно имеют в виду кандидоз — заболевание влагалища и вульвы, обусловленное грибами Candida (кандида).
В нашей клинике Вы можете пройти наиболее полноценное обследование при вагинальном кандидозе и молочнице. Для многих наших пациенток Клиника Современной Медицины стала последней инстанцией в решении этой проблемы. Мы поможем Вам избавиться от нее.
Известно, что большинство молодых женщин лечится от молочницы самостоятельно.
Однако доказано, что у 50% из них симптомы молочницы все равно возобновятся.
Зачем нужно обследоваться при молочнице?
Прежде всего, чтобы однозначно определиться с причиной заболевания.
Для многих женщин молочница — это характеристика любого воспаления во влагалище (кольпит, вагинит). Однако причин воспаления может быть много. Особое исследование показало, что только 1/3 женщин, самостоятельно лечившихся от молочницы, действительно имели кандидоз. У остальных были другие инфекционные или неинфекционные причины вагинита. Понятно, что самостоятельный прием противогрибковых средств при реальном отсутствии кандидоза бесполезен, а иногда и вреден.
Мы установим истинную причину Ваших симптомов. Но если и сейчас Вы уверены, что это именно кандидоз, обследование необходимо. Чтобы установить причину неэффективного лечения и рецидивов. Нужно найти верный подход к лечению. Для этого надо узнать особенности заболевания, его возбудителей и Вашего организма.
Разные возбудители кандидоза по-разному восприимчивы к противогрибковым препаратам. Такие виды, как Candida glabrata и Candida krusei устойчивы к наиболее распространенным препаратам, широко доступным в аптеках. Ваш грибок Candida может оказаться устойчивым. Чтобы выбрать правильную схему лечения, нужно установить Ваших возбудителей кандидоза.
В нашей клинике Вы можете пройти наиболее полную лабораторную диагностику кандидоза. Мы установим Ваш вид Candida из множества (более 20) вариантов и его уникальную чувствительность к противогрибковым средствам. Это позволит найти такую схему лечения, которая избавит Вас от грибка.
Кандидоз часто протекает как хроническое заболевание, с периодическими обострениями. Они заставляют женщину принимать разные медикаменты. Однако эффект этих средств ограничен. Они редко защищают от повторных обострений. В то же время, во влагалище многих женщин грибы Candida находятся постоянно и при этом не вызывают воспалительной реакции. Неужели Вам не повезло?
Правильный подход заключается в оценке индивидуальной реакции Вашего организма на присутствие Candida . Если Ваш иммунитет отказывается сдерживать натиск инфекции, и вместо нормального состояния влагалища Вы получаете эпизоды воспаления, мы можем установить именно Вашу реакцию на Candida и подсказать Вам верное решение. Только в Институте Аллергологии и Клинике Современной Медицины Вы можете пройти комплексный тест на определение гиперчувствительности к Candida . Это приоритетная разработка нашего института, внедренная специально для нас профессором А. Ю. Сергеевым, автором известной книги «Кандидоз». Тест позволяет установить более 6 типов индивидуальной реакции на Candida . С помощью теста Вы сможете узнать, ослаблен ли у Вас специфический иммунитет против Candida и есть ли у Вас аллергия на Candida . По результатам теста мы сможем разработать для Вас такую схему терапии, которая поможет Вашему организму самостоятельно справляться с кандидозом .
В нашем распоряжении находятся новейшие специфические препараты для лечения кандидоза и эффективные иммунокорригирующие средства. Их рациональное сочетание, выбранное по данным обследования специально для Вас, позволят Вам избавиться от кандидоза. Эффективность наших методов диагностики и лечения подтверждены специальными исследованиями. Ежегодно наш Институт и клиника внедряет и апробирует новейшие препараты, вылечивая многих пациенток с хроническим рецидивирующим кандидозом, включая осложненные и устойчивые к лечению формы. Наши специалисты имеют широкое признание и мировой приоритет в лечении кандидоза. Благодаря их работам лечение молочницы впервые стало надежным и эффективным. Вы сможете решить эту проблему, обратившись в нашу клинику.
Наш медицинский центр оказывает самый широкий спектр услуг. Вы всегда можете обратится к нам по вопросам лечения гинекологических заболеваний. Мы готовы оказать вам услуги лечения нарушений менструального цикла и лечения нарушений функции яичников.
Лечение кандидоза направлено на ослабление и устранение факторов риска (нарушений иммунной, эндокринной систем, заболеваний желудочно-кишечного тракта), проведение антимикотической терапии и восстановление нормального микроценоза влагалища. Этапами лечения вагинального кандидоза являются устранение симптомов и предотвращение рецидивов заболевания. Лечение кандидоза проводится препаратами местного и системного воздействия. Лечение вагинального кандидоза должно назначаться только врачом, любое самолечение недопустимо.

Лечение кандидоза направлено на ослабление и устранение факторов риска (нарушений иммунной, эндокринной систем, заболеваний желудочно-кишечного тракта), проведение антимикотической терапии и восстановление нормального микроценоза влагалища. Этапами лечения вагинального кандидоза являются устранение симптомов и предотвращение рецидивов заболевания. Лечение кандидоза проводится препаратами местного и системного воздействия. Лечение вагинального кандидоза должно назначаться только врачом, любое самолечение недопустимо.
Препараты для лечения кандидоза подбираются на консультации гинеколога с учетом вида грибка Candida и его уникальной восприимчивости к противогрибковым средствам. Самолечение, особенно при острой форме вагинального кандидоза, может привести лишь к временному улучшению и переходу заболевания в хроническую форму. Лечение вагинального кандидоза у беременных проводится только местными противогрибковыми средствами.
Терапия острого кандидоза
На время лечения кандидоза следует прекратить сексуальные контакты и прием антибиотиков, гормонов (эстрогенов, кортикостероидов), цитостатиков и т. д., отказаться от вредных привычек. При легкой форме вагинального кандидоза можно ограничиться местным лечением – применением вагинальных свечей или таблеток, содержащих клотримазол, эконазол, миконазол, кетоконазол, пимафуцин, нистатин и т. д. Введения во влагалище местных средств (свечей, кремов, растворов) лучше осуществлять на ночь. Также применяются ванночки и спринцевания противовоспалительными и дезинфицирующими растворами.
Вместо препаратов местного воздействия при остром течении кандидоза возможно однократное применение внутрь флуконазола. Через неделю рекомендуется повторный прием препарата в той же дозе.
Терапия рецидивирующего кандидоза
Лечение хронического течения кандидоза (более 4 рецидивов в год) направлено на коррекцию фоновой патологии, купирование рецидивов и проведение длительной супрессивной антимикотической терапии в поддерживающем режиме. С этой целью назначаются системные противогрибковые препараты: кетоконазол; флуконазол; итраконазол. Одновременно используются местные антимикотические средства: вагинальные таблетки или свечи с клотримазолом в течение 2-3 недель. Обычно клиническая гинекология использует схему, согласно которой интенсивное лечение при рецидивах кандидоза проводится в течение 14 дней с последующей супрессивной терапией длительностью до 6 месяцев.
Критериями излеченности вагинального кандидоза является исчезновение симптомов заболевания и отрицательные результаты микроскопии мазка через 10, 40 дней и 3 месяца. После проведения курса антимикотической терапии назначаются препараты, восстанавливающие нормальную влагалищную флору. С этой целью используется бифидумбактерин в виде влагалищных аппликаций на ночь в течение 8 дней (растворяют 5-10 доз бифидумбактерина в 10 мл кипяченой воды, в полученном растворе смачивают ватный тампон и помещают его во влагалище); вагинальные свечи ацилакт (по 1 суппозиторию на ночь в течение 10 дней). Одновременно проводится лечение биопрепаратами дисбактериоза кишечника.
В дополнение к основному лечению кандидоза может быть назначена терапия иммунокорректорами (иммунал, милайф, полиоксидоний и др.), но только после исследования иммунограммы. Вопрос о необходимости лечения полового партнера до настоящего времени остается открытым. Большинство специалистов склоняется к обязательному лечению партнера при рецидивирующей форме кандидоза у женщины или наличии клинических проявлений у самого партнера.
Стоимость терапии может существенно варьироваться, что обусловлено наличием острой и хронической инфекции различной степени тяжести. Цена лечения кандидоза в Москве зависит от формы заболевания, особенностей терапевтической программы (только местная терапия, сочетание средств общего и местного действия), наименований, продолжительности приема и дозировки противомикробных препаратов. При использовании иммунокорректоров и препаратов для лечения дисбактериоза кишечника общая стоимость лечения увеличивается. В частных центрах цена данной медицинской услуги, как правило, выше, чем в государственных лечебных учреждениях.
Кандидоз – это грибковое поражение кожного и слизистого покрова.
Причиной возникновения кандидоза и его симптомов это дрожжеподобный грибок, из рода Candida.
Грибки Candida живут на коже, слизистой и в кишечнике человека.

До определенного количества микроорганизмы не вызывают симптомов кандидоза.
Если превышен порог численности микроорганизмов, проявляется симптоматика.

У женщин и мужчин кандидозы могут протекать с разными симптомами.
Итак, вы подозреваете кандидоз, симптомы заболевания достаточно характерны:
- На кожном покрове появляются беловатые налеты;
- Могут быть признаки воспаления кожного покрова;
- Выраженный зуд кожного покрова;
- Жжение;
- Грибковые поражения имеют специфический запах.
Симптомы кандидоза лечит врач миколог или дерматолог.
При отсутствии лечения может распространяться, вплоть до генерализации.
Системный кандидоз это опасное для жизни состояние.
Кандидозы у мужчин: симптомы
Различные кандидозы у мужчин имеют специфические симптомы.
Самая неприятная локализация кандидоза у мужчин кандидоз — это процесс на члене.
Симптомы кандидоза на пенисе у мужчин:
- Краснота головки и крайней плоти;
- Налеты;
- Возможно образование участков эрозии;
- Возможны такие симптомы, как боль при мочеиспускании;
- Жжение;
- Характерны выделения белого цвета.
Если у мужчины появились подобные симптомы необходимо посетить врача!
При адекватной терапии симптомы кандидоза у мужчин полностью устранимы.
При отсутствии терапии обеспечены осложнения кандидоза: воспаление яичек и предстательной железы, фимоз и стриктуры уретры.
| Наименование | Срок | Цена |
|---|---|---|
| Прием венеролога | 900.00 руб. | |
| ДНК Candida albicans | 1 д. | 300.00 руб. |
Грибковые кандидозы у женщин имеют схожие симптомы.
Часто грибок поражает влажные и теплые места.
Он может расположиться в кожных складках, во рту или во влагалище.
Кандидоз влагалища или молочница имеет неприятные симптомы.
Симптомы кандидоза или молочницы у женщин могут быть следующими:
- I. Неприятный специфический запах;
- II. Жжение и дискомфорт;
- III. Выделения обильные, творожистого характера.
Симптомы кандидоза и молочницы можно достаточно легко устранить при помощи свечей и противогрибковых препаратов.
Важно: перед применением препарата проконсультируйтесь с врачом!
Кандидоз и молочница имеют симптомы, которые несколько похожи на признаки инфекционных заболеваний.
Кроме того, грибковое поражение влагалища может маскировать более опасные болезни.
Симптомы кандидоза у мужчин и женщин возникают довольно часто.
Почти половина взрослого населения минимум единожды сталкивалась с грибковыми заболеваниями.
Причины появления симптомов кандидоза следующие:
- Нарушение иммунного статуса пациента;
- Выраженный дисбактериоз кожного покрова;
- Систематическое применение таблеток и мазей с содержанием гормонов;
- Заражение грибками рода Кандида от полового партнера;
- Продолжительное применение антибиотиков;
- Хронические заболевания, например сахарный диабет;
- Инфицированность ВИЧ;
- Повышение индекса массы тела.
Помните: кандидоз — это заразное заболевание.
Кандидоз может передаваться контактным, бытовым и половым путем.
Наиболее комфортная среда для кандидозы — теплая и влажная.
Болезнь передается через влажные полотенца, мочалки.
Любимые места проявления симптомов кандидоза у мужчин и женщин:
- Крупные складки кожи: подмышки, пах;
- Области копчика;
- Половые органы;
- Ротовая полость;
- Кишечник.
Лечение кандидоза — применяется комбинированная терапия противогрибковыми препаратами.
Наиболее назначаемые лекарства это Нистатин, Пимафуцин и Флуконазол.
Помните! Противогрибковые лекарства можно применять только по назначению врача.
Если вы обнаружили у себя или у своих близких признаки кандидоза, необходимо срочно обратиться к доктору.
При подозрении на кандидоз обращайтесь к автору этой статьи – венерологу в Москве с 15 летним опытом работы.
Согласно статистике, вагинальный кандидоз составляет не менее 30% от общей частоты развития всех мочеполовых инфекций. Несмотря на кажущуюся легкость лечения этого заболевания, в чем нас периодически убеждает реклама, кандидоз требует внимательного отношения к себе. Ведь при отсутствии лечения или при самолечении он способен привести к развитию осложнений, с которыми сложно справиться.
Для выявления кандидоза в Международном медицинском центре ОН КЛИНИК применяют самые современные методы, которые позволяют провести полноценную диагностику в день обращения пациента. А для лечения врачи подбирают наиболее эффективные препараты, которые безопасны для организма.
Стоимость услуг
| Наименование услуги | Цена, руб. |
|---|---|
| Прием врача дерматовенеролога, первичный, амбулаторный | 2100 |
| Прием врача дерматовенеролога повторный, амбулаторный | 2100 |
| Консультация дерматовенеролога, кандидата медицинских наук | 2400 |
| Консультация дерматовенеролога, доктора медицинских наук, профессора | 3000 |
| Прием врача акушера-гинеколога первичный, амбулаторный | 2100 |
| Прием врача акушера-гинеколога повторный, амбулаторный | 2100 |
| Консультация врача акушера-гинеколога, кандидата медицинских наук | 2400 |
| Консультация врача акушера-гинеколога, доктора медицинских наук, профессора | 3000 |
| Прием врача уролога первичный, амбулаторный | 2100 |
| Прием врача уролога повторный, амбулаторный | 2100 |
| Консультация врача уролога, кандидата медицинских наук | 2400 |
| Консультация врача уролога, доктора медицинских наук, профессора | 3000 |
Диагностика и лечение кандидоза в ОН КЛИНИК
Диагностика молочницы проводится в два этапа. Сначала врач проводит внешний осмотр пациента, а затем назначает дифференциальную лабораторную диагностику. Обратившись в наш центр, будьте уверены – наши специалисты подскажут, как устранить факторы, которые в Вашем индивидуальном случае приводят к росту колоний грибков. А это значит, что Вам не придется постоянно сталкиваться с рецидивами этого заболевания, что случается при самолечении или лечении у врачей с низкой квалификацией.
Для лечения кандидоза применяются противогрибковые препараты системного воздействия, а также локально свечи и мази. Очень важно следовать всем рекомендациям врача-дерматовенеролога и не прерывать терапию даже в случае исчезновения видимых симптомов. Лечение необходимо проходить вместе с партнером.
В ОН КЛИНИК Вам предложат лечение молочницы, которое будет оказывать комплексное влияние на организм, оздоровит его и укрепит. Также врач даст ряд полезных советов по питанию и выбору нижнего белья (например, при кандидозе лучше носить белье исключительно из натуральных тканей).
Специалисты ОН КЛИНИК в любой день недели готовы оказать Вам поддержку при лечении любых заболеваний. Мы сделаем все возможное, чтобы к Вам как можно скорее вернулось здоровье и хорошее настроение!
Что такое кандидоз?
Кандидоз является группой грибковых заболеваний местной локализации, которые поражают кожу, слизистые и в некоторых случаях – внутренние органы. Возбудителями этой болезни являются дрожжевые грибки из рода Candida, отсюда и название. Также кандидоз называют молочницей, что связано с обильными выделениями белого цвета, характерными для этой патологии.
Кандидоз кожных покровов часто путают с аллергией, ведь он может проявляться в виде сыпи и язвочек. Попадая на микродефекты кожи, мелкие царапины и ранки, грибы Candida вызывают воспаление, зуд и жжение. Кандидоз слизистых оболочек рта чаще всего встречается у новорожденных и проявляется появлением белых творожистых выделений на языке и внутренней поверхности щек. При кандидозе кишечника наблюдается диарея с примесью белых хлопьев.
Урогенитальный кандидоз встречается как у женщин, так и у мужчин. Он создает дискомфорт, проявляется воспалением половых органов и препятствует ведению нормальной половой жизни.
Симптомы урогенитального кандидоза
У женщин молочница проявляется следующими признаками:
- обильные, молочного цвета выделения из половых путей, похожие на творог;
- неприятный запах;
- зуд, жжение в области половых органов, которые усиливаются после душа и по ночам;
- покраснение, отечность половых органов;
- дискомфорт во время полового акта, боли.
Мужчины, которые заразились грибками Candida, страдают от воспаления головки полового члена и крайней плоти, которое проявляется появлением сероватого налета, зудом и жжением.
Осложнения кандидоза
Отсутствие лечения молочницы или ее неправильная терапия может у женщин привести к заболеваниям шейки матки, мочеиспускательного канала и даже к бесплодию. У мужчин кандидоз может стать причиной заболеваний мочевыводящих путей, почек, мочевого пузыря, предстательной железы и семявыносящих протоков.
При подозрении на кандидоз не пытайтесь лечиться самостоятельно, не применяйте методы и препараты, которые когда-то помогли Вашим близким, ведь каждый пациент требует индивидуального подхода. Уделите себе немного времени и посетите врача в ОН КЛИНИК. И совсем скоро Вы забудете о неприятных симптомах!
Доверяйте Ваше здоровье профессионалам! ОН КЛИНИК
Кандидоз – что это такое
Кандидоз — это грибковое заболевание, которое преимущественно поражает слизистые оболочки и кожу, реже внутренние органы. Выделяют его разные формы: пищеварительной, дыхательной и мочеполовой систем, а также кожных покровов. Если иммунитет сильно ослаблен, может возникнуть кандидозный сепсис (он же генерализованный кандидоз), чреватый серьезными осложнениями.
Причины
Кандидоз вызывают грибы рода Кандида (Candida), представители нормальной микрофлоры слизистых оболочек. По определенным причинам они начинают интенсивно размножаться, нарушают естественный баланс кожи.
- физического контакта с носителем (при поцелуях, через руки, обсемененную посуду, продукты питания);
- дисбактериоза ротовой полости;
- нарушения иммунобиологической резистентности организма.
Кандидоз во рту часто диагностируется у беременных, недоношенных детей, ВИЧ-инфицированных, при туберкулезе, раковых заболеваниях, патологиях обмена веществ. Также благоприятные условия для размножения болезнетворных грибов создает пониженная кислотность желудочного сока, длительный прием антибактериальных препаратов.
Кандидоз желудка обычно развивается на фоне смешанной кишечной инфекции или дисбактериоза. Грибы Кандида начинают неконтролируемо размножаться. В результате образуются специфические грибковые токсины, ядовитые продукты ферментации. Слизистая желудка и кишечника воспаляется. Аналогичная картина наблюдается при кандидозе пищевода.
Вульвовагинальный кандидоз у женщин является следствием снижения защитных сил организма, нарушения микрофлоры. Также заболеванием можно заразиться при использовании обсемененных предметов личной гигиены, во время полового акта.
- беременных;
- женщин, которые принимают гормональные контрацептивы;
- столкнувшихся с заболеваниями эндокринной системы.
Кандидоз у мужчин, поражающий слизистую половых органов, встречается гораздо реже, чем у женщин, и обычно имеет вялое течение.
- дисбактериоз кишечника;
- снижение иммунитета;
- авитаминоз;
- повышенная потливость;
- сахарный диабет, ожирение;
- продолжительное лечение кортикостероидами, цитостатиками, антибиотиками.
Симптомы кандидоза
Симптомы кандидоза зависят от того, слизистые оболочки каких органов и систем поражены. Так, при возникновении молочницы ротовой полости пациент жалуется на появление молочно-творожистого налета на слизистых щек, неба, языка и губ. При его снятии обнажается эрозированная кровоточащая поверхность. Если лечение не будет начато вовремя, спинка языка станет ярко-красного цвета, воспалятся уголки рта, красная кайма губ. Чаще всего ротовая полость поражается кандидозом у детей и пожилых людей.
Кандидоз желудочно-кишечного тракта имеет свою симптоматику.
- Инвазивную фокальную (осложняет течение неспецифического язвенного колита, язвенной болезни двенадцатиперстной кишки). Инвазивный фокальный кандидоз можно заподозрить у больных с затяжным и не поддающимся лечению основным заболеванием.
- Инвазивную диффузную. У больного наблюдается выраженная интоксикация, сильные боли в животе, высокая температура. Могут быть примеси крови в стуле.
- Неинвазивную. Грибы не проникают в толщу кишечной стенки, а размножаются в просвете кишки. При этом пациент ощущает дискомфорт в животе, у него появляется метеоризм, неустойчивый стул.
Кандидоз влагалища может проявляться:
- бело-серыми обильными выделениями с кислым запахом;
- зудом и жжением в области вульвы (усиливаются после физической работы, во время месячных);
- болями при половом акте;
- отеком слизистой оболочки;
- появлением на слизистой очагов плохо счищаемых пленочек.
Если вагинальный кандидоз перешел в хроническую форму, выделения могут отсутствовать. Но на поверхности половых губ постоянно имеются сухие эрозии или скудные пленки, слизистые незначительно гиперемированы.
Кандидоз кожи поражает крупные кожные складки, половые органы, стопы, кисти, волосяные фолликулы подмышечных впадин, область усов и бороды у мужчин, область промежности у маленьких детей. Для него характерно появление пустул, папул, пузырьков, после вскрытия которых образуются мокнущие эрозии. Поверхность последних гладкая и блестящая, имеет белесоватый налет.
Если посмотреть на фото кандидоза разных форм, станет ясно, что во всех ситуациях у пациентов присутствует одинаковый симптом — творожистый налет белого цвета. Он существенно облегчает диагностику.
Диагностика
Диагностика кандидоза обычно не вызывает трудностей у врачей. Если грибы начали активно размножаться в полости рта, стоматолог осматривает слизистую и выявляет типичные для заболевания белесые очаги. Дополнительно им может быть проведено микроскопическое исследование соскоба. Для подбора лекарственных препаратов проводится тест на определение чувствительности.
Диагностика кандидоза половых органов выполняется гинекологами и урологами. Во время приема врач осматривает слизистые, берет анализ отделяемого из влагалища/пениса и отправляет его на бакпосев. Использование высокоточных лабораторных методик (ПЦР, ПИФ) в данной ситуации не актуально. Диагноз ставится, если выявляется факт интенсивного размножения возбудителей рода Кандида.
Диагностика кандидоза кожи заключается в выявлении грибов путем взятия соскоба с пораженного участка и исследования материала в условиях лаборатории.
Сложнее всего выявить молочницу желудочно-кишечного тракта и внутренних органов, поскольку визуально оценить характер очагов невозможно. При подозрении на заболевание пациенту назначают лабораторное обследование: анализ крови, анализ кала на дисбактериоз, бактериологическое исследование кала.
Для выбора эффективного и безопасного метода исследования кишечника больного направляют на консультацию к врачу-эндоскописту. Во время эндоскопии определяются неспецифические поражения слизистой, поэтому обязательна эндоскопическая биопсия, а также морфологическое исследование биоптатов.
Лечение кандидоза
Лечение кандидоза ротовой полости у взрослых и детей предусматривает использование местных и общих методов.
- устранение сопутствующих заболеваний (если таковые имеются);
- санацию и обработку очагов;
- укрепление иммунитета.
Если подтверждено наличие кандидоза кишечника, лечение назначается с учетом имеющихся сопутствующих патологий, клинического варианта и переносимости лекарственных средств. Обязательно проводится устранение фоновой патологии, модуляция иммунитета.
В ходе лечения кандидоза половых органов проводятся мероприятия общего и местного характера. Выбор подходящего метода определяется тяжестью заболевания. При легких формах обычно используются местные препараты, при тяжелых — дополнительно назначаются лекарства общего действия.
Если очаги небольшие, вылечить кандидоз кожи можно просто с помощью местных мазей или лазера. При тяжелой форме местное лечение дополняют таблетками.
Диета
Иногда, чтобы вылечить кандидоз, нужно только скорректировать питание. Цель диеты состоит в том, чтобы лишить грибки Кандида необходимых им питательных веществ.
- фруктовых соков;
- сладостей;
- сахарной свеклы;
- сахара;
- меда;
- алкоголя.
Под запретом также кукуруза, тыква, морковь, картофель.
Опасность
Прогноз кандидоза кожи и слизистых оболочек — благоприятный. Если лечение проведено грамотно, рецидивы обычно не возникают. Только запущенная молочница может перейти в хроническую форму.
Если же речь о диффузном инвазивном кандидозе кишечника, то высок риск генерализации патологического процесса. Ситуацию осложняют имеющиеся у больного сопутствующие заболевания.
Группа риска
- плохо питаются;
- не соблюдают правила гигиены полости рта;
- ведут беспорядочную половую жизнь;
- болеют онкопатологиями, аллергическими и аутоиммунными заболеваниями;
- лечатся гормонами;
- имеют болезни ЖКТ.
Также в группу риска по кандидозу входят беременные женщины, дети в возрасте до двух лет, пожилые люди — все категории населения, у которых ослаблен или еще не сформирован иммунитет.
Профилактика
- закаливание организма;
- прием витаминов;
- соблюдение правильного режима питания;
- санацию ротовой полости;
- своевременное выявление и лечение дисбактериоза;
- исключение необоснованного приема гормонов и антибиотиков;
- отказ от употребления большого количества углеводов.
Читайте также:








